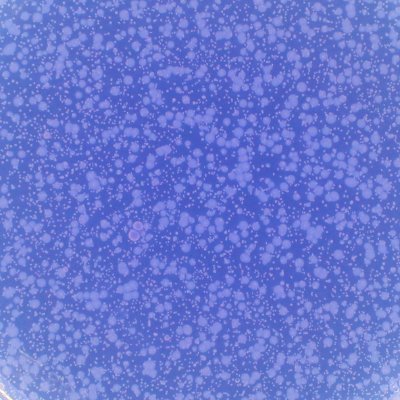

Evaporative cooling, our most efficient form of heat loss, is underpinned by nuanced biophysics. This @ExpPhysiol review explores how energy thresholds and the statistical behaviour of molecules interact with the environment to drive evaporation. physoc.onlinelibrary.wiley.com/doi/10.1113/EP…
The team at @UBCKin find that healthy #aging is key to #exercise and respiratory function in males and females, The metabolic cost of breathing for exercise ventilations: effects of age and sex (Shalaya Kipp et al.): ow.ly/yKPq50WBuNo

Top Cited Article: #Lactate as a #myokine and #exerkine: drivers and signals of #physiology and #metabolism (ow.ly/WFNP50WvewT)

The art of sharing: From research to outreach in the social media era. Interested in science dissemination? This is for you 👇🏼 physoc.onlinelibrary.wiley.com/doi/10.1113/EP… @ExpPhysiol @CRESP_Research
👋 Call for Letters - Submit your LTE about “Viewpoint: Durability, Fatigability, Repeatability and Resilience in Endurance Sports: Definitions, Distinctions, and Implications.” Read the Call for Letters requirements: ow.ly/EWyB50WmgLV.
Congratulations to Drs. Gungor-Orhan, Akin, Olgaz-Bingol, and Demirel for their outstanding study on the effects of a sedentary lifestyle on skeletal muscle atrophy published in Experimental Physiology (2025) doi.org/10.1113/EP0923…
Some thoughts on heading the ball and brain health in women's football: southwales.ac.uk/news/2025/july…

🚨CALL FOR PAPERS🚨 We are looking for submissions for our "New approaches for old diseases" special issue, which will focus on novel mechanisms of action underlying long-lasting ageing-related cardiometabolic conditions & the new lifestyle therapies. 🔗 buff.ly/ECNxMp2

New Viewpoint in @japplphysiol Durability, Fatigability, Repeatability and Resilience in Endurance Sports: Definitions, Distinctions, and Implications journals.physiology.org/doi/abs/10.115…
Research Article by JP Hartmann and @NymandStine et al. (@CRESP_Research) #Pulmonary adaptations to 12 wk of supervised high intensity interval training in #COPD: a nonrandomized controlled pilot study #hiit #exercisetherapies ow.ly/LRjt50WaWRT

Out today - Power and Endurance: Polar Opposites or Willing Partners? in Medicine & Science in Sports & Exercise. journals.lww.com/acsm-msse/abst…
Sean Roe (@QueensBiomed) discusses his 2024 Paton Prize-winning lecture on Gordon Holmes and the Irish spirit of adventure in our latest #EPicks. Check it out through the link below! 📽️ buff.ly/5ydLlN6 Read the full article: 📜 buff.ly/L6cduMO

physoc.onlinelibrary.wiley.com/doi/10.1113/EP… Athletes have higher stroke volume - during rest related to longer diastole (similar filling rate), but during exercise ... read more in our paper now with full/free text @ExpPhysiol
💊CALL FOR PAPERS💊 We are looking for submissions to our "The Neurobiology of Placebo effects" special issue, which will bring cutting-edge research that explores the underlying neurobiological mechanism of placebo effects in various contexts! 🔗 buff.ly/foL47XS

"Mind the gap (again!): On the challenges for women in physiology". An important and timely #Editorial from Christina Yfanti of Centre for Physical Activity Research, @Rigshospitalet. ♀️🥼 buff.ly/oH0tU7f

Can emphysema be repaired? What started as a bold idea from Steve Rennard led to the creation of ASTE (Advanced Study to Treat Emphysema). Our first publication is out, laying the groundwork for the approach we’re taking to tackle this challenge. #cureCOPD 🔗Link here:…

New paper on mitochondrial distribution across the human body If you have more mitochondria than the average person in your heart, does that mean you also have more than average in your brain, muscles, kidneys, etc? We investigated inter-organ correlations in mitochondria 🧵

🚨CALL FOR PAPERS🚨 For our "Integrative physiological considerations of the human vasculature system" #SpecialIssue, which will showcase insights into vascular haemodynamics and multi-organ diseases. 🔗 buff.ly/HN7wlPr

In this recent study, Denis J. Wakeham (@UTSWMedCenter) et al. investigated functional sympatholysis of neuropeptide Y-mediated #vasoconstriction in humans 🫀🏃 📜 Read the #Research here: buff.ly/VYNVPm9

Fantastic story. Read more to find out about a scientific partnership that would shape the future of nutritional science!
Yesterday we unveiled a blue plaque at King’s College Hospital to honour the pioneering nutritional physiologist and dietitian, Dr Elsie May Widdowson. Read our news article to find out more ⬇️ buff.ly/awdbmCi @KingsCollegeLon
United States 趨勢
- 1. Jets 77.9K posts
- 2. Jets 77.9K posts
- 3. Justin Fields 7,917 posts
- 4. Aaron Glenn 4,210 posts
- 5. #HardRockBet 3,285 posts
- 6. Sean Payton 1,859 posts
- 7. London 200K posts
- 8. Garrett Wilson 3,152 posts
- 9. Bo Nix 2,951 posts
- 10. HAPPY BIRTHDAY JIMIN 138K posts
- 11. Tyrod 1,515 posts
- 12. #OurMuseJimin 185K posts
- 13. #DENvsNYJ 2,044 posts
- 14. #JetUp 1,890 posts
- 15. Peart 1,884 posts
- 16. #30YearsofLove 162K posts
- 17. Bam Knight N/A
- 18. Kurt Warner N/A
- 19. Hail Mary 2,379 posts
- 20. Rich Eisen N/A
Something went wrong.
Something went wrong.